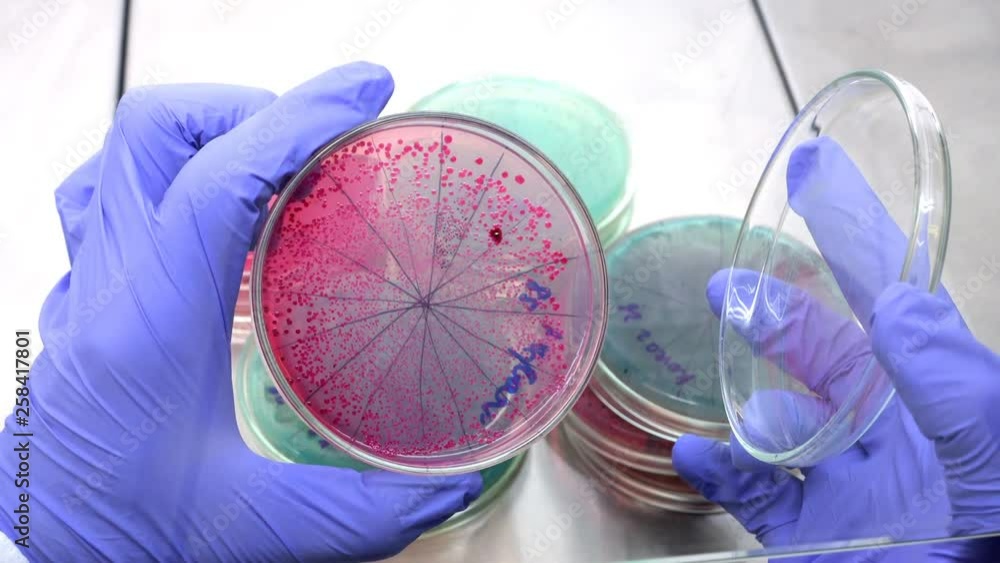

Red Bacteria In Dishwasher . serratia bacteria are airborne and are commonly found in moist areas of the home such as showers, bathtubs, sinks, toilets, and pet water dishes. our dishwasher has been plagued with red bacteria also known as pink slime. if you notice pink mold growth in your dishwasher, you should get rid of it immediately by dismantling it and cleaning every part of the. A recent study published in applied and environmental. what kind of bacteria are living in your dishwasher? dishwasher microbial communities are seeded by tap water, which contains bacteria picked up from the plumbing system, and by microbes and food. the first and most crucial step in eliminating serratia marcescens from your dishwasher is a thorough cleaning and disinfection. it's caused by serratia marcescens, a bacteria that has what's called an adhesive cell matrix, which means it thrives as a colony and.
from stock.adobe.com
our dishwasher has been plagued with red bacteria also known as pink slime. A recent study published in applied and environmental. what kind of bacteria are living in your dishwasher? it's caused by serratia marcescens, a bacteria that has what's called an adhesive cell matrix, which means it thrives as a colony and. the first and most crucial step in eliminating serratia marcescens from your dishwasher is a thorough cleaning and disinfection. serratia bacteria are airborne and are commonly found in moist areas of the home such as showers, bathtubs, sinks, toilets, and pet water dishes. dishwasher microbial communities are seeded by tap water, which contains bacteria picked up from the plumbing system, and by microbes and food. if you notice pink mold growth in your dishwasher, you should get rid of it immediately by dismantling it and cleaning every part of the.
Bacteria red on agar. A scientist opens a Petri dish and examines red
Red Bacteria In Dishwasher what kind of bacteria are living in your dishwasher? our dishwasher has been plagued with red bacteria also known as pink slime. if you notice pink mold growth in your dishwasher, you should get rid of it immediately by dismantling it and cleaning every part of the. serratia bacteria are airborne and are commonly found in moist areas of the home such as showers, bathtubs, sinks, toilets, and pet water dishes. what kind of bacteria are living in your dishwasher? the first and most crucial step in eliminating serratia marcescens from your dishwasher is a thorough cleaning and disinfection. A recent study published in applied and environmental. it's caused by serratia marcescens, a bacteria that has what's called an adhesive cell matrix, which means it thrives as a colony and. dishwasher microbial communities are seeded by tap water, which contains bacteria picked up from the plumbing system, and by microbes and food.
From stock.adobe.com
Bacteria red on agar. A scientist opens a Petri dish and examines red Red Bacteria In Dishwasher A recent study published in applied and environmental. our dishwasher has been plagued with red bacteria also known as pink slime. if you notice pink mold growth in your dishwasher, you should get rid of it immediately by dismantling it and cleaning every part of the. what kind of bacteria are living in your dishwasher? serratia. Red Bacteria In Dishwasher.
From www.youtube.com
🔬 114 How to reduce the bacteria in your dishwasher YouTube Red Bacteria In Dishwasher serratia bacteria are airborne and are commonly found in moist areas of the home such as showers, bathtubs, sinks, toilets, and pet water dishes. dishwasher microbial communities are seeded by tap water, which contains bacteria picked up from the plumbing system, and by microbes and food. A recent study published in applied and environmental. what kind of. Red Bacteria In Dishwasher.
From www.youtube.com
What temp kills bacteria in dishwasher? YouTube Red Bacteria In Dishwasher it's caused by serratia marcescens, a bacteria that has what's called an adhesive cell matrix, which means it thrives as a colony and. what kind of bacteria are living in your dishwasher? if you notice pink mold growth in your dishwasher, you should get rid of it immediately by dismantling it and cleaning every part of the.. Red Bacteria In Dishwasher.
From www.buzzle.com
Different Types of Bacteria Red Bacteria In Dishwasher if you notice pink mold growth in your dishwasher, you should get rid of it immediately by dismantling it and cleaning every part of the. A recent study published in applied and environmental. our dishwasher has been plagued with red bacteria also known as pink slime. it's caused by serratia marcescens, a bacteria that has what's called. Red Bacteria In Dishwasher.
From mamaadventure.com
Dishwasher full of weird red stuff? Fix it! Mama Adventure Red Bacteria In Dishwasher serratia bacteria are airborne and are commonly found in moist areas of the home such as showers, bathtubs, sinks, toilets, and pet water dishes. what kind of bacteria are living in your dishwasher? our dishwasher has been plagued with red bacteria also known as pink slime. the first and most crucial step in eliminating serratia marcescens. Red Bacteria In Dishwasher.
From www.scienceprofonline.org
Does the Dishwasher Kill Bacteria on Dishes? Home Experiment Red Bacteria In Dishwasher dishwasher microbial communities are seeded by tap water, which contains bacteria picked up from the plumbing system, and by microbes and food. the first and most crucial step in eliminating serratia marcescens from your dishwasher is a thorough cleaning and disinfection. if you notice pink mold growth in your dishwasher, you should get rid of it immediately. Red Bacteria In Dishwasher.
From susansgreencleaning.com
Prevent Mold, Yeast, And Bacteria Growth In Your Dishwasher Seattle Red Bacteria In Dishwasher the first and most crucial step in eliminating serratia marcescens from your dishwasher is a thorough cleaning and disinfection. our dishwasher has been plagued with red bacteria also known as pink slime. what kind of bacteria are living in your dishwasher? if you notice pink mold growth in your dishwasher, you should get rid of it. Red Bacteria In Dishwasher.
From www.huffpost.com
Your Dishwasher Is Probably Crawling With Bacteria And Fungus Red Bacteria In Dishwasher our dishwasher has been plagued with red bacteria also known as pink slime. it's caused by serratia marcescens, a bacteria that has what's called an adhesive cell matrix, which means it thrives as a colony and. serratia bacteria are airborne and are commonly found in moist areas of the home such as showers, bathtubs, sinks, toilets, and. Red Bacteria In Dishwasher.
From es.dreamstime.com
Colonias Bacterianas Rojas En Una Placa De Petri Aislada En Negro Red Bacteria In Dishwasher if you notice pink mold growth in your dishwasher, you should get rid of it immediately by dismantling it and cleaning every part of the. dishwasher microbial communities are seeded by tap water, which contains bacteria picked up from the plumbing system, and by microbes and food. what kind of bacteria are living in your dishwasher? A. Red Bacteria In Dishwasher.
From www.dishwasherhero.com
Cleaning Archives DishwasherHero Red Bacteria In Dishwasher A recent study published in applied and environmental. what kind of bacteria are living in your dishwasher? the first and most crucial step in eliminating serratia marcescens from your dishwasher is a thorough cleaning and disinfection. if you notice pink mold growth in your dishwasher, you should get rid of it immediately by dismantling it and cleaning. Red Bacteria In Dishwasher.
From gephardtdaily.com
Study IDs bacteria and fungi found in dishwashers Gephardt Daily Red Bacteria In Dishwasher dishwasher microbial communities are seeded by tap water, which contains bacteria picked up from the plumbing system, and by microbes and food. if you notice pink mold growth in your dishwasher, you should get rid of it immediately by dismantling it and cleaning every part of the. it's caused by serratia marcescens, a bacteria that has what's. Red Bacteria In Dishwasher.
From www.shutterstock.com
Red Bacterial Colonies Escherichia Coli On Stock Photo 274277558 Red Bacteria In Dishwasher if you notice pink mold growth in your dishwasher, you should get rid of it immediately by dismantling it and cleaning every part of the. our dishwasher has been plagued with red bacteria also known as pink slime. A recent study published in applied and environmental. what kind of bacteria are living in your dishwasher? the. Red Bacteria In Dishwasher.
From steelcleandishwasher.com
Preventing Bacterial Growth In Your Dishwasher Cleanliness Enthusiast Red Bacteria In Dishwasher our dishwasher has been plagued with red bacteria also known as pink slime. dishwasher microbial communities are seeded by tap water, which contains bacteria picked up from the plumbing system, and by microbes and food. if you notice pink mold growth in your dishwasher, you should get rid of it immediately by dismantling it and cleaning every. Red Bacteria In Dishwasher.
From www.dreamstime.com
Red Bacterial Colonies on Petri Dish Isolated on Black Background Stock Red Bacteria In Dishwasher it's caused by serratia marcescens, a bacteria that has what's called an adhesive cell matrix, which means it thrives as a colony and. the first and most crucial step in eliminating serratia marcescens from your dishwasher is a thorough cleaning and disinfection. dishwasher microbial communities are seeded by tap water, which contains bacteria picked up from the. Red Bacteria In Dishwasher.
From www.shutterstock.com
Red Bacteria Serratia Marcescens Growing On Stock Photo 1694681443 Red Bacteria In Dishwasher it's caused by serratia marcescens, a bacteria that has what's called an adhesive cell matrix, which means it thrives as a colony and. A recent study published in applied and environmental. what kind of bacteria are living in your dishwasher? our dishwasher has been plagued with red bacteria also known as pink slime. dishwasher microbial communities. Red Bacteria In Dishwasher.
From www.shutterstock.com
Red Bacterial Colonies On Petri Dish Stock Photo 286362689 Shutterstock Red Bacteria In Dishwasher if you notice pink mold growth in your dishwasher, you should get rid of it immediately by dismantling it and cleaning every part of the. our dishwasher has been plagued with red bacteria also known as pink slime. A recent study published in applied and environmental. dishwasher microbial communities are seeded by tap water, which contains bacteria. Red Bacteria In Dishwasher.
From pngtree.com
Harm Clipart Transparent Background, Red Harmful Bacteria Illustration Red Bacteria In Dishwasher the first and most crucial step in eliminating serratia marcescens from your dishwasher is a thorough cleaning and disinfection. dishwasher microbial communities are seeded by tap water, which contains bacteria picked up from the plumbing system, and by microbes and food. if you notice pink mold growth in your dishwasher, you should get rid of it immediately. Red Bacteria In Dishwasher.
From www.sciencephoto.com
Bacteria from a domestic dishwasher, SEM Stock Image C037/8020 Red Bacteria In Dishwasher it's caused by serratia marcescens, a bacteria that has what's called an adhesive cell matrix, which means it thrives as a colony and. dishwasher microbial communities are seeded by tap water, which contains bacteria picked up from the plumbing system, and by microbes and food. A recent study published in applied and environmental. if you notice pink. Red Bacteria In Dishwasher.